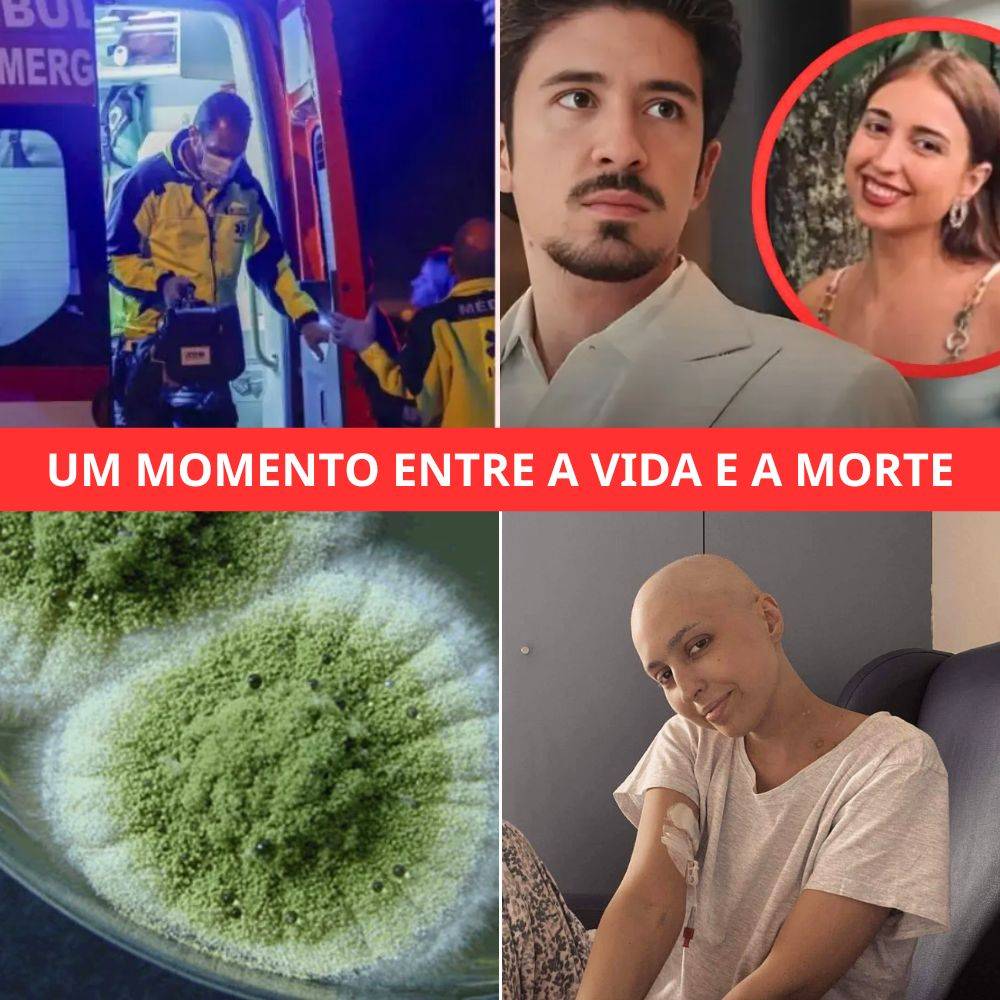

24 December 2025
The debut of the Duchess of Sussex’s lifestyle series has ignited a firestorm of criticism, with royal commentators and television reviewers delivering a unanimous and devastating verdict. The highly anticipated Netflix show, “With Love,…

24 December 2025
Berlin, 19 grudnia 2016 roku. Ciężarówka Scania na polskich tablicach wbija się w tłum na świątecznym jarmarku. W chaosie i zniszczeniu ginie 12 osób, kilkadziesiąt zostaje rannych. Wśród ofiar jest polski kierowca, Łukasz Urban,…

24 December 2025
UM MOMENTO ENTRE A VIDA E A MORTE: O especialista em doenças infecciosas Chris Kosmidis contactou diretamente Angela Pereira através da Numeiro e de um amigo próximo, reacendendo a esperança no meio do desespero.…

24 December 2025
W sprawie śmierci 14-letniego Piotrka Malika coraz częściej powraca jedno zdanie, które nie daje spokoju opinii publicznej: „chłopca przesłuchał policjant – nie wzywając matki”. To właśnie ten fragment relacji rodziny stał się punktem zapalnym…

24 December 2025
A silent emissary from a bygone era has delivered its final visual testimony from the void, and its parting gift is a profound redefinition of our cosmic isolation. For over 46 years, NASA’s Voyager…

24 December 2025
“OUVI-O CHORAR… DEPOIS SILÊNCIO” — NAMORADA DE NUNO MARKL FICA SEM FÔLEGO E LIGA PARA O SAÚDE APÓS ÚLTIMA CHAMADA QUE DEIXOU PORTUGAL SEM RESPOSTA! A frase ecoa como um sussurro gelado. “Ouvi-o chorar……